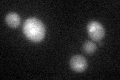

View description
Serine/threonine kinase and DNA damage checkpoint effector, mediates cell cycle arrest via phosphorylation of Pds1p; phosphorylated by checkpoint signal transducer Mec1p; homolog of S. pombe and mammalian Chk1 checkpoint kinase
Localization:
Intensity:
Fold change:
Significance:
-
C’ GFP library in SD

below threshold15.66 -
N' NOP1pr-GFP in SD

cytosol,nucleus87.6084 -
N' TEF2pr-mCherry in SD

nucleus85.1196 -
N' NATIVEpr-GFP in SD

below threshold20.214 -
N' TEF2pr-VC and Cyto-VN in SD

cytosol33.3008 -
C’ GFP library in SD+DTT
cytosol19.371.23No -
C’ GFP library in SD+H2O2

cytosol18.751.19No -
C’ GFP library in Starvation Media

cytosol14.860.94No -
C’ GFP library on the background of Pup2-DaMP

below threshold -
C’ GFP library on the background of CCT mutant

below threshold17.62191.1247No
